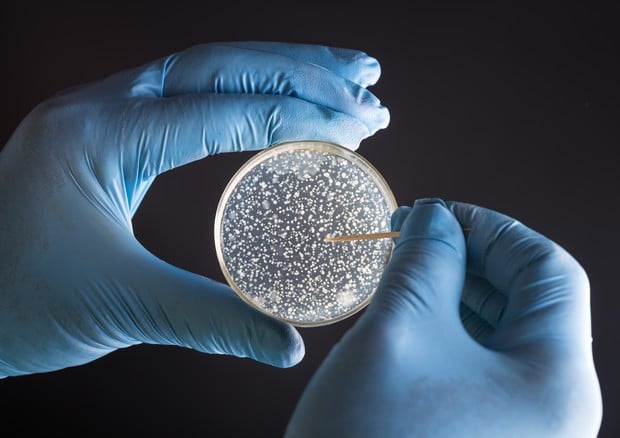

Sono sessantaquattro i pazienti che in tutta la Toscana – da novembre dell’anno scorso ad oggi – sono stati infettati dal “New Delhi”, batterio scoperto nel 2009 e particolarmente resistente agli antibiotici. Un batterio pericoloso sopratutto per i pazienti fragili, già colpiti da altre patologie o immunodepressi.
A tracciare il quadro è stata l’assessore regionale alla salute Stefania Saccardi, nel pomeriggio di ieri a Firenze. Saccardi ha ribadito che vanno ‘evitati gli allarmismi’ tanto che – già da mesi, ricorda l’assessore, ‘sono state messe in atto le misure necessarie per conoscere meglio il fenomeno ma soprattutto ridurne l’estensione’.
Attenzione dunque anche negli ospedali dove sono aumentati ad esempio gli screening all’ingresso dei pazienti, effettuati con un tampone rettale ed estesi a tutti i reparti di medicina, ripetuti settimanalmente per tutta la degenza nel caso di esito negativo: ad oggi 546 sono risultati i portatori del batterio in tutta la regione. Ma solo una piccola parte appunto, meno del dieci per cento, ha accusato infezioni e sintomi: 49 nell’Asl nord ovest, quindici nelle altre due aree vaste toscane. Un solo caso a Careggi, nessuno a Prato ed Empoli.
“Il fenomeno – sottolinea ancora Saccardi – è stato fronteggiato tempestivamente dalla strutture sanitarie regionali. Non c’è stata alcuna sottovalutazione e il nostro obiettivo in questo momento è la prevenzione”.
L’unità di crisi, composta da più esperti di infezioni, ha messo a punto una serie di indicazioni operative fornite a tutte le Asl e agli ospedali toscani, con indirizzi omogenei e comuni. Gli screening, che la Toscana regolarmente effettuava nei reparti di terapia intensiva o laddove l’anemnesi dei pazienti li consigliava, sono stati estesi. E tutti i dati raccolti sono stati inseriti all’interno di un database, per una successiva indagine retrospettiva.
Una precisazione, arriva poi dalla direzione sanità ossia che non è possibile stabilire un nesso causale diretto, nella maggior parte dei casi, tra contrazione dell’infezione e morte, perché si tratta di una concausa che va ad agire su condizione cliniche già compromesse: pazienti magari che già accusano insufficienze renali, diabetici o con altre patologie, in molti casi anziani.
Riguardo al batterio, invece, gli esperti spiegano che con questo è possibile anche ‘convivere’ per tutta la vita. Si tratta infatti di batteri che normalmente fanno parte della flora intestinale umana e che, solo in taluni casi, diventano resistenti appunto agli antibiotici. Questo batterio passa da una persona all’altra per contatto. Per questo la profilassi da seguire è quella igienica, dal lavarsi le mani all’uso di presidi e strumenti monouso, fino all’isolamento del paziente, e deve riguardare non solo gli operatori ma i ricoverati stessi e i parenti che si recano in ospedale a far loro visita.